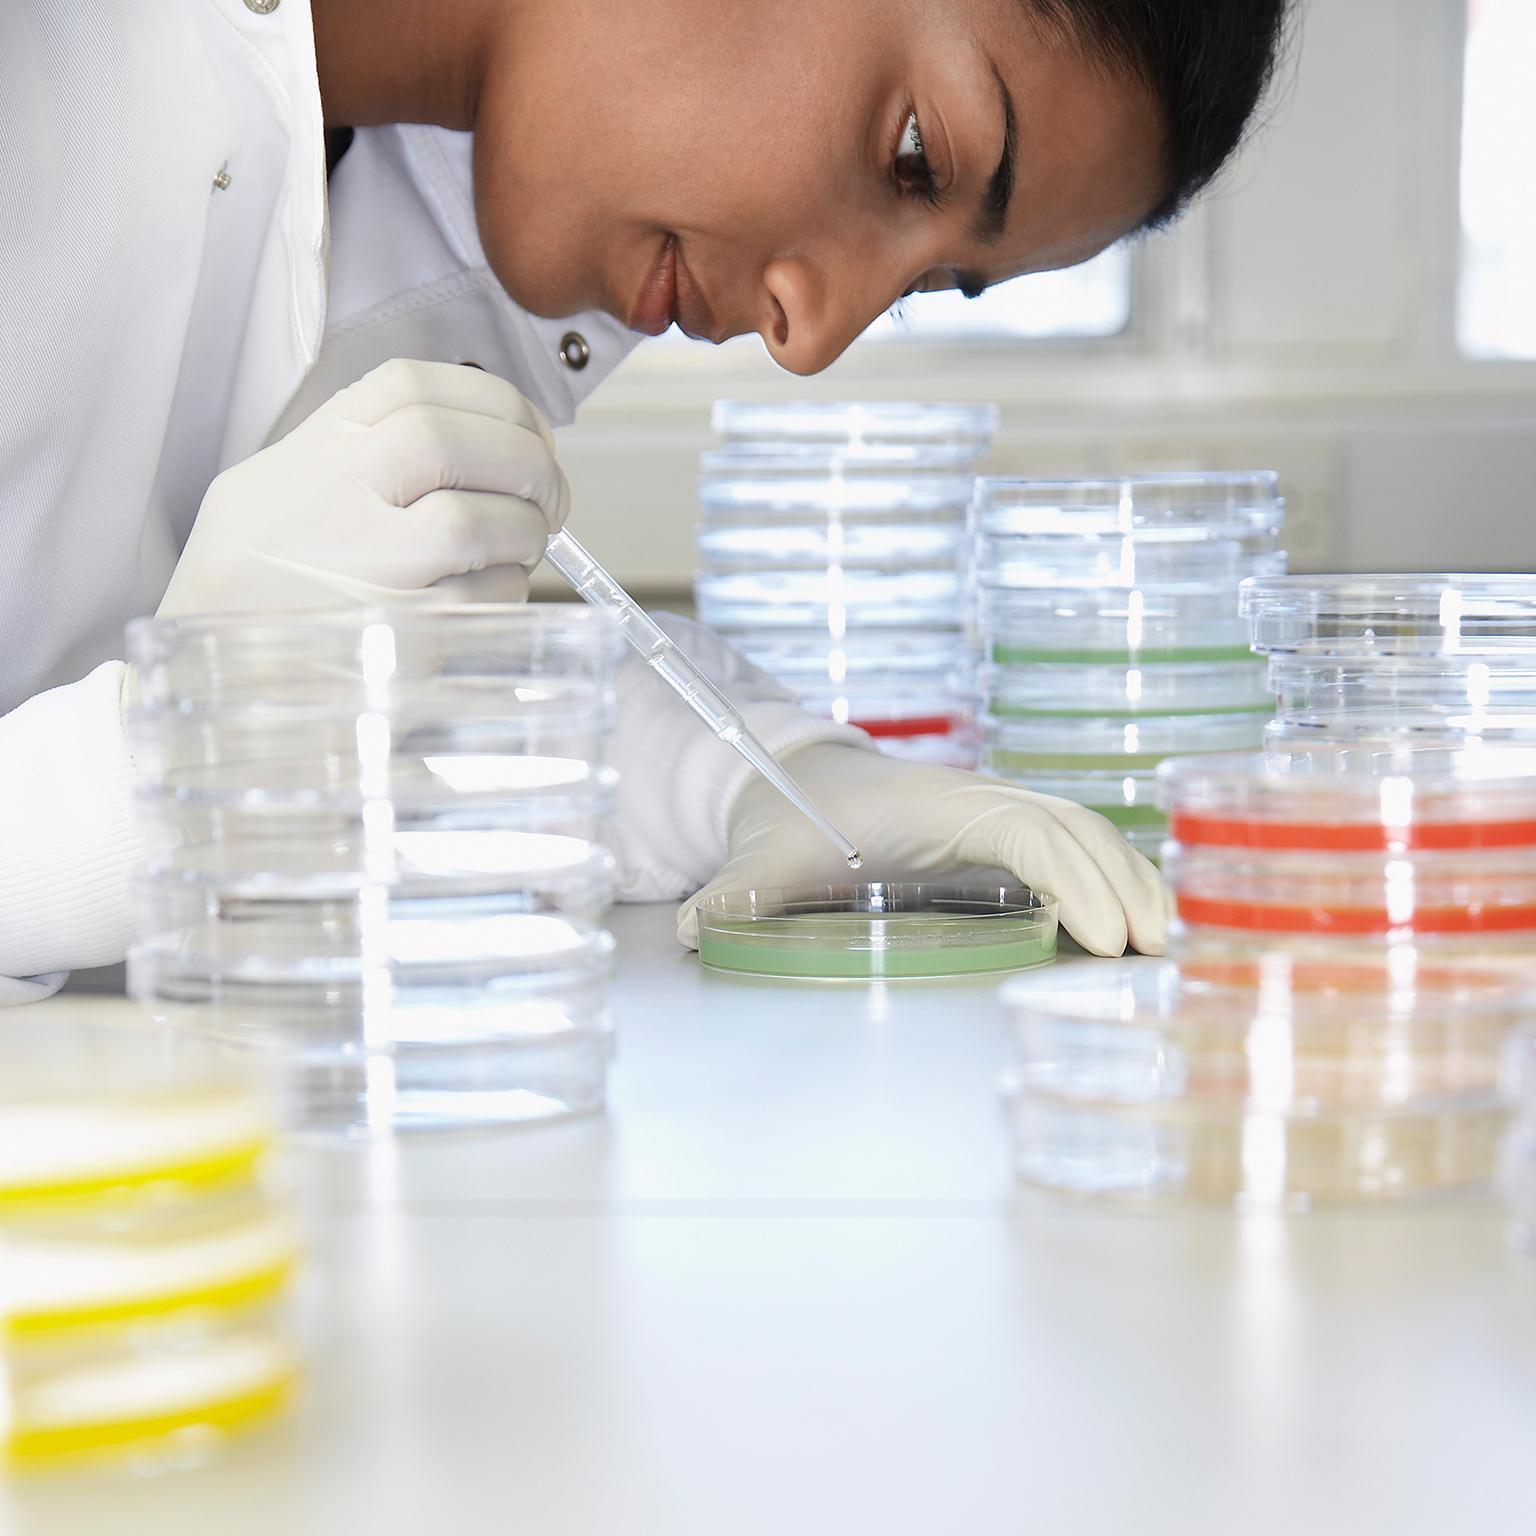

How is the relationship between patients and pharma businesses changing? In this interview, Ron Cohen, the CEO of biotechnology company Acorda Therapeutics, explains how digitization is changing the nature of consumer engagement and how he has sought to embed new technologies and create a culture of risk taking within his organization. An edited transcript of the interview follows.
Interview transcript
When I grew up in the industry, things were pretty well set in terms of how pharmaceutical companies engaged with patients—which is to say that you didn’t engage all that much.
But now, for various reasons, that has changed. It’s changed because various patient groups have insisted that it change—and rightly so. Today, patients are demanding more of a say in the type of care they get, the type of medicines that are being developed, how the medicines are going to be applied to them, and what the regulatory pathway should be.
When you put all this together, it’s clear that there needs to be a brand-new level of deep engagement with the patients for your drugs, starting at the very early parts of development all the way through to commercialization and beyond. The good news is that all of this is coinciding with a revolution in digital technology and social media—in the ability to reach people with particular characteristics all over the world.
Digitizing collaboration and engagement
At Acorda Therapeutics, we have been approaching this need to integrate the patient in a number of ways. One of them is not digital—one of them is good old-fashioned face-to-face engagement with patient groups and patient ambassadors. We can interact with them to learn about their needs and also educate them about what we’re doing. Just because we have digital, it doesn’t mean that there isn’t a need for the other piece. In fact, you need them both to be successful.
A few years ago, I started a digital-innovation-and-strategy group at the company because it was clear that we could integrate digital into everything we were doing, including our internal operations, as well as our clinical development, our commercial marketing, and our drug development.

How pharma companies can better understand patients
I engaged with the leadership team, such as the head of commercial, the head of clinical and medical, the head of R&D, and our internal creative staff—all the people who report to me. And over time, we identified the areas that we wanted to focus on. For example, the medical-affairs team engaged with the digital-strategy group to develop a way to integrate more closely with our patient community.
And so our group developed a self-health application called MS self, and it’s one of the most popular apps now for the multiple-sclerosis community. Users can track various metrics about what’s going on with their health—how they are walking, how they are thinking that day, what their diet is like, how much exercise they’re getting, and so on. It has provided a tool for our patient community to use, and thousands of people have already downloaded the app. Second, they get to know Acorda, so we then have a contact point with the community.
Embracing the digital vision
So it starts with the leadership. I believed this as CEO of the company. My job was to go and talk to the leadership team. And, yes, there was resistance. The commercial group, say, came out of the historical school of how you market a drug—for example, you take out advertisements in the journals. Digital was not part of their world as they grew as professionals and excelled and became executive vice presidents of commercial and chief commercial officers.
However, if you have the right people in the leadership on your teams, that shouldn’t matter so much. Because if they’re the right people, they are focused on “How can I get this job done the absolute best I can? And what tools are available, even if I’ve never used them before?” Because your job is always to think about how do we do it better. And if new tools come in, you better embrace those tools and try them and see if they’ll work for you. Well, our chief commercial officer was willing to do that, and she made sure that her team was willing to do that.
You also need a culture that not only forgives failures and mistakes but embraces them and encourages risk taking. That sort of culture really helps when you’re trying to get digital integrated.
Setting up your digital team for success
For the first two years we had the digital-innovation-and-strategy group, I had the executive director report directly to me. When people see that something’s important enough to the CEO that [a team is] reporting to him or her, they begin to pay attention. And furthermore, in those two years, I was able to craft the vision for what I wanted digital to do in the company together with the team, because it was reporting directly to me.
Adopting a test-and-learn approach
The old saw about advertising is “I know half of my budget is wasted. I just don’t know which half.” Well, with digital marketing, we have, for example, much better ways of tracking the efficiency and effectiveness of the different concepts that we try online. And we’ve actually extended that into other areas in the company.
So, for example, we are now recruiting for our clinical studies with the help of digital marketing. We’ve taken the same multichannel techniques and we’ve turned them on to find people with a particular condition—let’s say, Parkinson’s disease or stroke—to inform them about the clinical trial. And then the individual can click through and figure out how to get into the trial. We’ve had hundreds of people call in to be in our trials as a result. This is something brand new.
So we can measure that, right? We launch a campaign, and then you see how many people are calling in. That’s pretty clear. Even with our commercial efforts for our drug AMPYRA, we can try different campaigns and measure each channel used and the tweaks on each one. And you can track who’s clicking through and what are they doing when they get there. Then we look to determine whether these behaviors are likely to predict an action that’s beneficial. This means that patients will go and talk to their doctors about whether the drug is right for them.